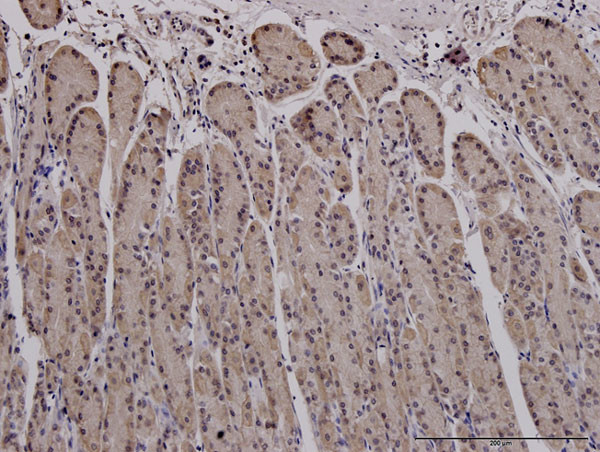
MUC4 Antibody in Immunohistochemistry (Paraffin) (IHC (P))

Search
Abnova
MUC4 Monoclonal Antibody (5B12)
{{$productOrderCtrl.translations['antibody.pdp.commerceCard.promotion.promotions']}}
{{$productOrderCtrl.translations['antibody.pdp.commerceCard.promotion.viewpromo']}}
{{$productOrderCtrl.translations['antibody.pdp.commerceCard.promotion.promocode']}}: {{promo.promoCode}} {{promo.promoTitle}} {{promo.promoDescription}}. {{$productOrderCtrl.translations['antibody.pdp.commerceCard.promotion.learnmore']}}
产品信息
H00004585-M07J
种属反应
宿主/亚型
分类
类型
克隆号
抗原
偶联物
形式
浓度
规格
纯化类型
保存液
内含物
保存条件
运输条件
产品详细信息
Sequence of this protein is as follows: GVSLFPYGAD AGDLEFVRRT VDFTSPLFKP ATGFPLGSSL RDSLYFTDNG QIIFPESDYQ IFSYPNPLPT GFTGRDPVAL VAPFWDDADF STGRGTTFYQ EYETFYGEHS
Cell culture grade monoclonal antibodies are obtained by purifying "hybridoma culture medium" which completely eliminates any contamination of mice. They have high affinity, high purity, and no contamination.
靶标信息
Nearly all mucosal surfaces are protected by mucin transmembrane glycoproteins, from bronchioles to corneas to reproductive tracts. Mucin 4 (MUC4) is membrane-bound and is important in protecting and lubricating. MUC4 expression is erroneous in many carcinomas and sarcomas, including fibromyoxoid sarcoma and pancreatic adenocarcinoma. Immunohistochemical staining for MUC4 has been discussed as a potential biomarker for detection of these cancers. MUC4 seems to be most predominantly affected in Asian diseases - Taiwanese infertility and endometriosis, as well as gallstone formation in Chinese men, are connected to MUC4, where similar diseases in other populations do not share these MUC4 mutations. Because MUC4 is so important in mucosal surface protection, it is not surprising that it has been implicated as failing in many metastatic cancer invasions.
仅用于科研。不用于诊断过程。未经明确授权不得转售。
篇参考文献 (0)
生物信息学
蛋白别名: Ascites sialoglycoprotein; ASGP; ASGP1; MUC-4; MUC4; mucin 4, tracheobronchial; Mucin-4; Mucin4; Pancreatic adenocarcinoma mucin; Testis mucin; Tracheobronchial mucin
基因别名: ASGP; HSA276359; MUC-4; MUC4
UniProt ID: (Human) Q99102
Entrez Gene ID: (Human) 4585